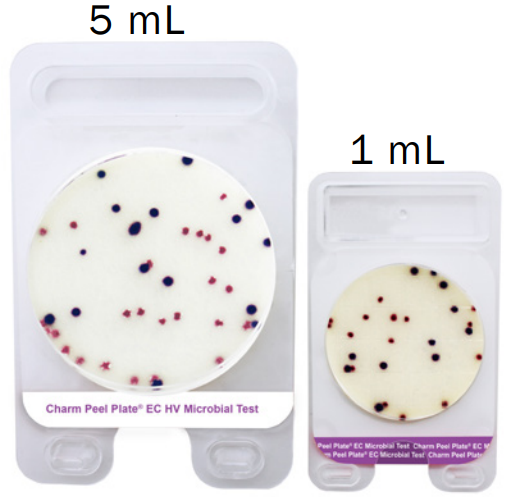

El medio de la prueba Peel Plate ECHV está basado en medio selectivo convencional para cultivar y diferenciar colorimétricamente el crecimiento de coliformes y E. coli en muestras de productos lácteos incubadas a 32°C por 24 ± 2 horas y de alimentos no lácteos, muestras ambientales y de agua incubadas a 35°C por 24 ± 2 horas.
La prueba Peel Plate ECHV contiene el sustrato enzimático salmon-gal (6-cloro-3-indolyl-B-Dgalactopiranosido) usado para detectar ß-galactosidasa producida por coliformes y x-glucuronido (5-bromo-4cloro-3-indoil-B-D-glucuronido) usado para detectar ß-glucuronidasa producida por E. coli.
Beneficios
- E-coli es un miembro del grupo coliformes y se diferencia colorimétricamente por colonias color azul, púrpura o verdoso a 35°C. Otros coliformes presentarán colonias rojas (salmón).
- No se necesita de accesorios para difundir la muestra (difusor)
- Las colonias se recogen fácilmente para obtener más aislamiento / clasificación.
- No se requiere interpretación de gas / ácido


- Detecta y enumera coliformes totales incluyendo E. coli en un volumen de 5 mL.
- El límite de detección del método es 1 o más unidades formadoras de colonia por 5 mililitros (ufc/5 mL) de muestra.
- La prueba Peel Plate EC HV es aplicable en productos lácteos líquidos (e.g. crema, leches saborizadas)
- Productos lácteos sólidos (e.g. crema agria, helado, suero condensado)
- Productos lácteos cultivados (fermentados) como queso cottage, yogurt, etc. requieren la placa Peel Plate EC-CD-HV – E. coli Cultured Dairy High Volume.
- Esponjas ambientales de superficie, agua de proceso de lavado de frutas/ vegetales cuando se requiere un nivel de sensibilidad de 1 a 154 UFC/5 mL.
Procedimiento
1

Levante
2

Pipetee verticalmente
3

Selle
Charm Peel Plate
Las pruebas Charm Peel Plate son placas microbianas de métodos de cultivo simplificados para la detección de microorganismos, cuentan con la certificación de la AOAC-RI en donde se garantiza el desempeño de las pruebas AC (Aerobios), EC (E-coli coliformes), YM (Mohos y Levaduras). Asi como también la prueba EB, (Enterobacterias), recibió la certificación MicroVal armonizada con la AOAC en “The Official Method of Analysis First Action Status”.
Para alimentos lácteos las pruebas Charm Peel Plate AC (Aerobios), CC (Coliformes), EC (E-coli coliformes) y Cultured dairy CC y EC cuentan con la aprobación FDA/NCIMS.

Las pruebas de Peel Plate se utilizan en productos lácteos, carnes molidas, otros alimentos, superficies ambientales de contacto y agua. Peel Plate cuenta con pruebas de 1 ml de volumen, para bacterias aeróbicas (prueba Peel Plate AC), recuento heterotrófico (prueba Peel Plate HET) y Staphylococcus Aureus (prueba Peel Plate SA). También cuenta con pruebas de 1 ml y 5 ml (High Volume) para el recuento de coliformes (prueba Peel Plate CC), coliformes / E. coli (prueba Peel Plate EC), enterobacteriaceae (prueba Peel Plate EB) y levaduras y mohos (prueba Peel Plate YM
